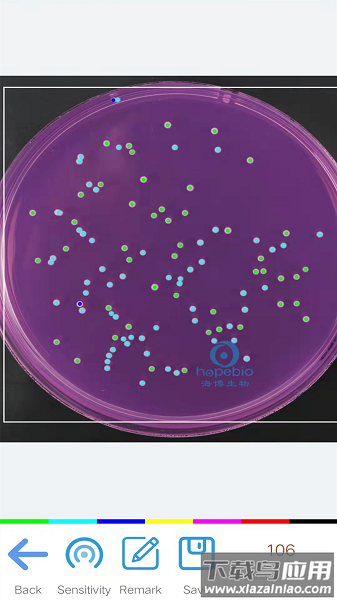

精点相机app专注于办公场景应用,借助先进技术快速分析照片中的物品数量,用户无需手动计数即可获得高度准确的结果;该工具支持同时解析多张图像,显著提升数据统计效率,适用于各类需要批量计数的实际工作需求。
精点相机手机版介绍
该应用将人工智能技术与移动终端深度融合,把计算机视觉能力集成于手机端,能够对上传图片进行智能分析并自动计算图中物品数量;与传统图像识别方式相比,它在处理效率和准确率方面都具有明显优势。

软件特色
1. 配备人工校正功能,允许用户对识别结果进行手动调整;
2. 具有区域圈选工具,可实现更精准的局部识别;
3. 支持实时拍摄与相册导入两种图像获取方式;
4. 内置历史记录模块,所有统计结果都能保存备查。
软件优势
1. 采用专业级人工处理技术,有效降低工作强度与操作难度;
2. 大幅节省统计时间,帮助用户快速完成计数任务;
3. 能在极短时间内完成数量清点,提升工作效率;
4. 避免重复性劳动带来的枯燥感,使计数过程变得轻松高效。
精点相机官方版亮点
1. 支持多类别精细区分统计,能辨别高度相似物品的差异;
2. 不受物体尺寸限制,可同时统计不同规格的物品;
3. 实现多品类同步统计,自动分类计算各类物品数量;
4. 对复杂形态物体具备准确识别能力,适应多种应用场景。
更新日志
修复已知系统问题,优化用户体验。

谷歌相机最新版
v9.4.103.641377609.23/
谷歌相机最新版
v9.4.103.641377609.23/ MT Photos安卓免费版
V1.36.2/
MT Photos安卓免费版
V1.36.2/ 幻颜秀秀安卓直装版
V2.3.9/
幻颜秀秀安卓直装版
V2.3.9/
 PSGo通用版
V1.0.0/
PSGo通用版
V1.0.0/ 海星水印相机直装版
V5.7.8/
海星水印相机直装版
V5.7.8/ Sora视频剪辑手机最新版
V1.1/
Sora视频剪辑手机最新版
V1.1/ 彩虹多多原版
V1.4.6/
彩虹多多原版
V1.4.6/ 恶搞P图官方版
V1.3/
恶搞P图官方版
V1.3/ 零一视频助手安卓官方版
V1.2/
零一视频助手安卓官方版
V1.2/ 视频制作王手机正版
V1.2.0/
视频制作王手机正版
V1.2.0/


















